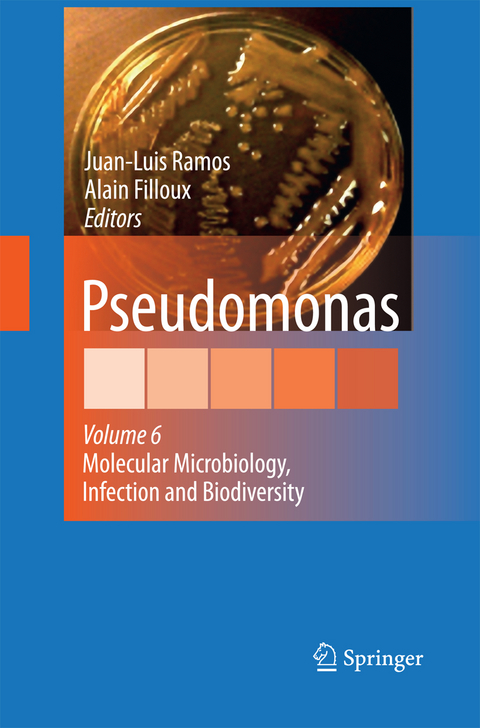
Pseudomonas -

Pseudomonas
Volume 6: Molecular Microbiology, Infection and Biodiversity
Seiten
2014
|
2010 ed.
Springer (Verlag)
978-94-007-9164-0 (ISBN)
Springer (Verlag)
978-94-007-9164-0 (ISBN)
Paris is a cosmopolitan city where roaring life, wonderful museums and excellent science can be found. It was during the XI IUMS conference held in this city that the Pseudomonas book series was ?rst envisaged. On the ?rst row of the auditorium sat a group of outstanding scientists in the ?eld, who after devoting much of their valuable time, contributed in an exceptional manner to the ?rst three volumes of the series, which saw the light simultaneously. The volumes were grouped under the generic titles of “Vol. I. Pseudomonas: Genomics, Life Style and Molecular Architecture”, Vol. II. Pseudomonas: Virulence and gene regulation; Vol. III. Pseudomonas: Biosynthesis of Macromolecules and Molecular Metabolism. Soon after the completion of the ?rst three volumes, a rapid search for ar- cles containing the word Pseudomonas in the title in the last 10 years produced over 6,000 articles! Consequently, not all possible topics relevant to this genus were covered in the three ?rst volumes. Since then two other volumes were p- lished: Pseudomonas volume IV edited by Roger Levesque and Juan L. Ramos that came to being with the intention of collecting some of the most relevant emerging new issues that had not been dealt with in the three previous volumes. This v- ume was arranged after the Pseudomonas meeting organized by Roger Levesque in Quebec (Canada). It dealt with various topics grouped under a common heading: “Pseudomonas: Molecular Biology of Emerging Issues”.
Regulation and Control of Virulence.- Small RNAs of Pseudomonas spp..- 2-Alkyl-4(1H)-Quinolone Signalling in Pseudomonas aeruginosa.- Cell-Surface Signalling in Pseudomonas.- Second Messenger c-di-GMP Signaling in Pseudomonas aeruginosa.- Life Styles.- Emergence of Pseudomonas aeruginosa in Cystic Fibrosis Lung Infections.- Insights into the Life Styles of Pseudomonas stutzeri.- Physiology, Metabolism and Markers.- Pyoverdine Siderophores as Taxonomic and Phylogenic Markers.- Metabolism of Acyclic Terpenes by Pseudomonas.- Heavy Metal Resistance in Pseudomonads.
| Erscheint lt. Verlag | 6.11.2014 |
|---|---|
| Zusatzinfo | XII, 287 p. |
| Verlagsort | Dordrecht |
| Sprache | englisch |
| Maße | 155 x 235 mm |
| Themenwelt | Medizin / Pharmazie ► Medizinische Fachgebiete ► Mikrobiologie / Infektologie / Reisemedizin |
| Studium ► 2. Studienabschnitt (Klinik) ► Humangenetik | |
| Naturwissenschaften ► Biologie ► Mikrobiologie / Immunologie | |
| ISBN-10 | 94-007-9164-X / 940079164X |
| ISBN-13 | 978-94-007-9164-0 / 9789400791640 |
| Zustand | Neuware |
| Informationen gemäß Produktsicherheitsverordnung (GPSR) | |
| Haben Sie eine Frage zum Produkt? |
Mehr entdecken
aus dem Bereich
aus dem Bereich
An International System for Human Cytogenomic Nomenclature (2024)
Buch | Hardcover (2024)
Karger (Verlag)
CHF 119,00
Eine sehr persönliche Geschichte | Der New York Times-Bestseller
Buch | Softcover (2023)
Ullstein Taschenbuch Verlag
CHF 30,75
Buch | Softcover (2022)
John Wiley & Sons Inc (Verlag)
CHF 169,95


